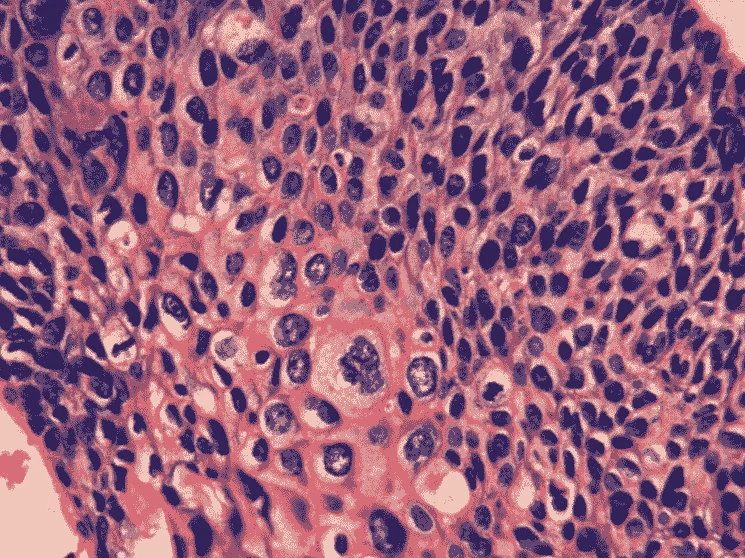
Phenix XSP-36

Биологический микроскоп Phenix XSP-36 (1600x) с камерой-окуляром (5 Мп)
Характеристики Phenix XSP-36
Общие данные
Основные характеристики
Оптические характеристики
Иммерсионный
Цифровые возможности
Подсветка и освещение
Встроенные функции и опции
Конденсор
Конструкция и удобство
Точная
Общие характеристики
Комплектация
объектив 40x – 1 шт
объектив 100x – 1 шт
окуляр WF10x – 2 шт
окуляр H16x – 2 шт
камера-окуляр (5 Мп) – 1 шт
часовое стекло – 1 шт
металлический ключ – 1 шт
иммерсионное масло (кедровое) – 1 шт
инструкция по эксплуатации – 1 шт
Габариты и вес
Описание Phenix XSP-36
Технические характеристики Phenix XSP-36
| Материал оптики | оптическое стекло |
| Револьверное устройство | на 3 объектива |
| Окуляры | WF10x, H16x |
| Увеличение микроскопа | 1600 крат |
| Рабочее расстояние | 185 мм (при 10x), 40 мм (при 100x), 0.3 мм (при 360x) |
| Диаметр поля зрения | 18 мм (при 10x), 1.8 мм (при 100x) |
| Тип насадки | бинокулярная |
| Угол наклона визуальной насадки | 30° |
| Регулируемое межзрачковое расстояние | 55 - 75 мм |
| Фокусировка |
грубая: 20 мм тонкая: 1,3 мм |
| Метод исследования | светлое поле, иммерсионный метод |
| Конденсор Аббе | наибольшая числовая апертура 1,25 |
| Предметный столик | координатный с препаратодержателем |
| Источник света | светодиодная подсветка с регулировкой яркости |
| Питание | 95 - 250 В |
| Тип микроскопа | стереоскопические / инструментальные, световые / оптические |
| Дополнительно | камера-окуляр (5 Мп) |
| Общие характеристики | |
| Цвет | белый |
| Габариты предметного столика | 115 x 125 мм |
| Габариты упаковки | 330 х 200 х 435 мм |
| Вес брутто | 4,45 кг |
| Комплектация |
микроскоп Phenix XSP-36 объектив 10x – 1 шт объектив 40x – 1 шт объектив 100x – 1 шт окуляр WF10x – 2 шт окуляр H16x – 2 шт камера-окуляр (5 Мп) – 1 шт часовое стекло – 1 шт металлический ключ – 1 шт иммерсионное масло (кедровое) – 1 шт инструкция по эксплуатации – 1 шт |
| Совместимость |
Видеоокуляр SAGA SJ-U200 Окулярная камера MC-D200U(E) для микроскопа Окулярная камера MC-D130U для микроскопа 1.3 Мп |
Обзорная таблица биологических микроскопов Phenix XSP-36
| Характеристики | Phenix XSP-36 (2000x) | Phenix XSP-36 (1600x) | Phenix XSP-36 (1600x) с камерой-окуляром (2 Мп) | Phenix XSP-36 (1600x) с камерой-окуляром (5 Мп) |
| Материал оптики | оптическое стекло | |||
| Револьверное устройство | на 3 объектива | |||
| Объективы | 10x, 40x, 100x | |||
| Окуляры | WF10x, WF16x, WF20x | WF10x, WF16x | WF16x, WF10x | WF10x, H16x |
| Увеличение микроскопа | 100 - 2000 крат | 1600 крат | 1600 крат | 1600 крат |
| Рабочее расстояние | - | - | - | 185 мм (при 10x), 40 мм (при 100x), 0.3 мм (при 360x) |
| Диаметр поля зрения | - | - | - | 18 мм (при 10x), 1.8 мм (при 100x) |
| Тип насадки | бинокулярная | |||
| Угол наклона визуальной насадки | 30° | |||
| Регулируемое межзрачковое расстояние | 55 - 75 мм | |||
| Фокусировка | грубая: 20 мм, тонкая: 1,3 мм | |||
| Дополнительно | - | - | камера-окуляр (2 Мп), USB | камера-окуляр (5 Мп) |
Микроскоп Phenix XSP-36 (1600x) с камерой-окуляром (5 Мп)
Стереоскопический биологический микроскоп для лабораторных исследований Phenix XSP-36 создает регулируемое увеличение микропрепаратов и подходит для разнопрофильных лабораторий. Увеличение микроскопа достигает 1600 крат.
Оптика модели изготовлена из оптического стекла. Прибор создан как инструмент для широкой области применения. Ниже — ответы на возможные вопросы о приборе.
Как устроена оптическая схема этого микроскопа?Бинокулярная насадка содержит окуляры WF10x, H16x для комфортной работы обоими глазами. Револьверное устройство на 3 объектива помогает быстро менять увеличение без потери фокуса на образце.
Какие инструменты доступны для настройки резкости?Фокусировка реализована в двух режимах - грубая на 20 мм точная на 1,3 мм. Такой подход создает четкое изображение препарата при том или ином увеличении.
Какие способы исследования доступны?Метод исследования, поддерживаемый моделью, обуславливает работу в светлом поле, также доступен иммерсионный метод для детального анализа образцов. Встроенный осветитель формирует равномерную подсветку в поле зрения.
Как происходит документирование исследований?Камера-окуляр с разрешением 5 Мп передает изображение на компьютер для архивации результатов.
Специалисты, которым подойдет такой микроскоп:- врачи-лаборанты клинических лабораторий;
- преподаватели биологии в учебных заведениях;
- медперсонал ветеринарных клиник.
- исследование клеточных структур тканей;
- анализ бактериальных культур и колоний;
- изучение простейших микроорганизмов;
- определение морфологии клеток;
- подсчет форменных элементов крови;
- оценка качества микропрепаратов.

Документация и ПО Phenix XSP-36
Отзывы Phenix XSP-36





Приехало все в целости, соответствует описанию, работает прекрасно. На больших увеличениях фокусируется хорошо, конденсор сидит прочно. Светодиоды мощные. нареканий не имею, спасибо
Добрый день, Василий!
Благодарим вас за отзыв! Мы рады, что ваш заказ пришел в целости и соответствует описанию. Очень приятно знать, что микроскоп Phenix XSP-36 хорошо работает и оправдал ваши ожидания по качеству сборки и своей функциональности.
Мы всегда стремимся предоставлять качественные продукты и радовать наших клиентов!
Искренне надеемся ещё не раз встретить вас на supereyes.ru.
С уважением и наилучшими пожеланиями, Администрация интернет-магазина Суперайс
Сотрудничаем с коммерческими организациями и государственными бюджетными учреждениями.
Работаем по прямому договору и участвуем во всех видах конкурентных процедур в рамках 44-ФЗ и
223-ФЗ. Оказываем помощь в составлении технического задания на оборудование.
Заполните форму и получите всю нужную информацию о выбранном оборудовании в виде коммерческого предложения:
- актуальные цены и сроки поставки;
- информация о скидке;
- наличие на наших складах.
С этим товаром покупают
Похожие товары
Ранее просмотренные Вами
Благодарственные письма










 Доставка
Доставка
 Оплата
Оплата
 Для бизнеса
Для бизнеса































